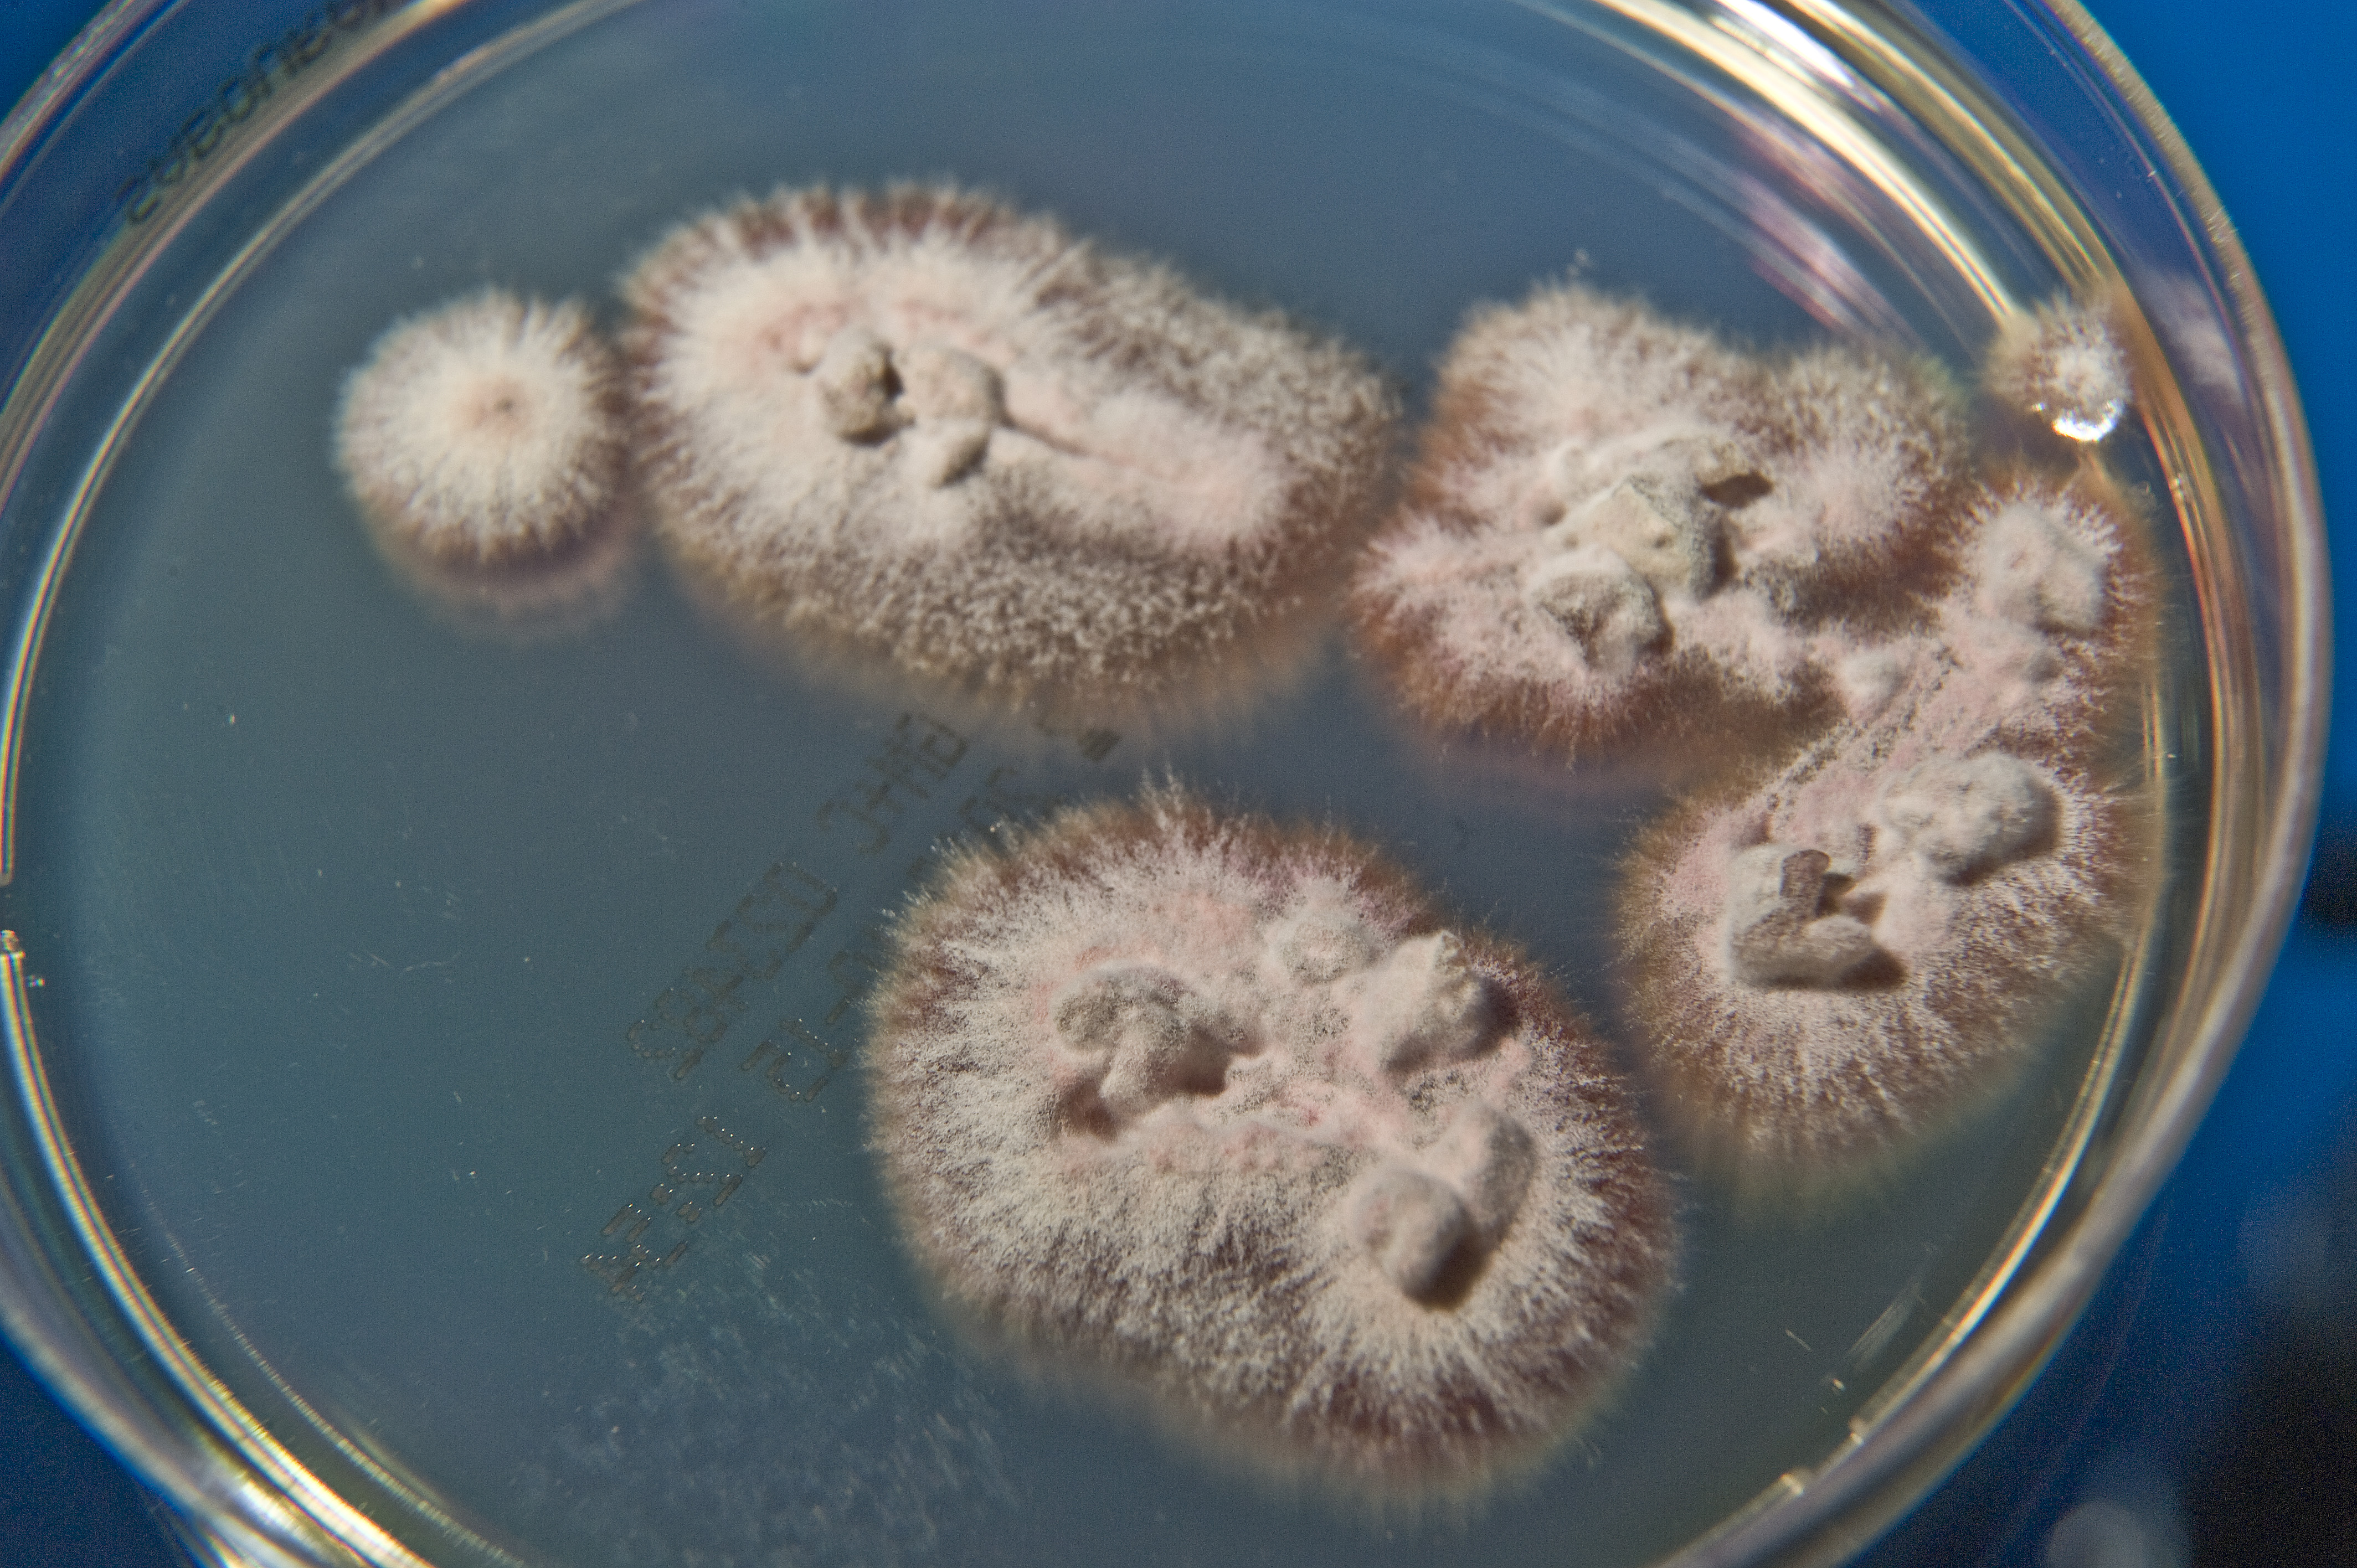
None
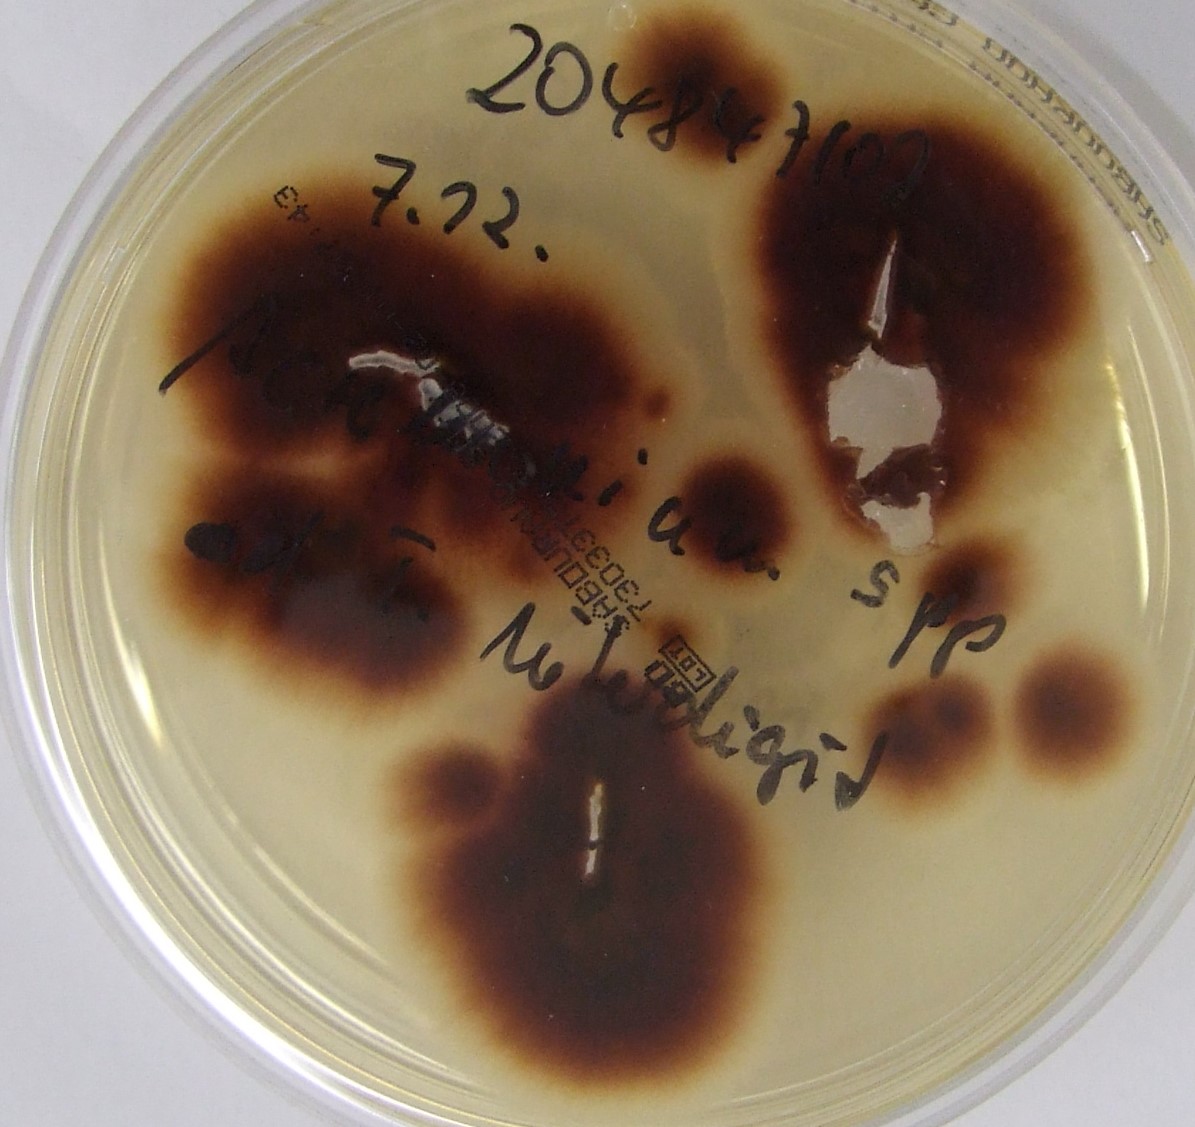
None

Arthroderma thuringiensis (Koch) Gräser & de Hoog 1969
Der wahrscheinlich ubiquitär im Erdboden, und dadurch auch im Fell von Erd- bewohnenden Tieren zu findende geophile Dermatophyt Arthroderma (A.) thuringiensis wurde erstmals im Jahr 1969 in Thüringen in Deutschland als neue Spezies Trichophyton (T.) thuringiense beschrieben. Entsprechend der neuen Taxonomie und Nomenklatur von 2017 wird T. thuringiense heute jedoch als Arthroderma thuringiensis (Koch) Gräser & de Hoog, comb. nov. klassifiziert und benannt.